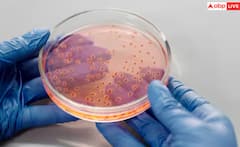
ਕੁੜੀਆਂ ਦੀ ਇਸ ਗਲਤੀ ਕਰਕੇ ਹੁੰਦੀ ਯੂਰਿਨ ਇਨਫੈਕਸ਼ਨ, ਨਹੀਂ ਪਤਾ ਹੋਵੇਗਾ ਤੁਹਾਨੂੰ

ਪੜਚੋਲ ਕਰੋ
Infection
ਸਿਹਤ

ਪੇਟ ਖਰਾਬ ਹੋਣ 'ਤੇ ਵਾਰ-ਵਾਰ ਕਿਉਂ ਆਉਂਦਾ ਪਿਸ਼ਾਬ? ਜਾਣੋ ਕਿਹੜੀਆਂ ਚੀਜ਼ਾਂ ਦਾ ਕਰਨਾ ਚਾਹੀਦਾ ਪਰਹੇਜ਼
ਵਿਸ਼ਵ

ਟਰੰਪ ਪ੍ਰਸ਼ਾਸਨ ਵੱਲੋਂ ਵੱਡਾ ਫੈਸਲਾ, ਅਮਰੀਕਾ 'ਚ ਇਨ੍ਹਾਂ ਲੋਕਾਂ ਦੀ ਐਂਟਰੀ ਬੰਦ! ਜਾਣੋ ਹੈਰਾਨੀਜਨਕ ਵਜ੍ਹਾ...
ਅਜ਼ਬ ਗਜ਼ਬ

Death: ਸਿਰ ਦੀਆਂ ਜੂੰਆਂ ਨੇ ਲਈ ਕੁੜੀ ਦੀ ਜਾਨ! ਮਾਪਿਆਂ ਲਈ ਵੱਡੀ ਚੇਤਾਵਨੀ, ਜ਼ਰੂਰ ਦਿਓ ਧਿਆਨ...
ਦੇਸ਼

ਆਨਲਾਈਨ ਡੇਟਿੰਗ ਐਪ ਰਾਹੀਂ ਫੈਲਿਆ HIV ਇਨਫੈਕਸ਼ਨ, 2 ਬੱਚਿਆਂ ਦਾ ਪਿਤਾ ‘ਗੇਅ’ ਨਾਲ ਸਰੀਰਕ ਸੰਬੰਧ ਬਣਾਉਣ ਤੋਂ ਬਾਅਦ ਹੋਇਆ ਸੰਕਰਮਿਤ; ਖੁਲਾਸੇ ਤੋਂ...
ਸਿਹਤ

ਔਰਤਾਂ 'ਚ ਵ੍ਹਾਈਟ ਡਿਸਚਾਰਜ ਕਦੋਂ ਹੁੰਦਾ ਖਤਰਨਾਕ? ਕਦੋਂ ਤੱਕ ਹੁੰਦਾ ਨਾਰਮਲ
ਸਿਹਤ

ਹੈਰਾਨੀਜਨਕ ! ਹਰ 9 ਵਿੱਚੋਂ 1 ਭਾਰਤੀ ਕਿਸੇ ਨਾ ਕਿਸੇ ਬਿਮਾਰੀ ਤੋਂ ਪੀੜਤ, ICMR ਦੀ ਹੈਰਾਨ ਕਰਨ ਵਾਲੀ ਰਿਪੋਰਟ
ਲਾਈਫਸਟਾਈਲ

ਅੱਖਾਂ ‘ਤੇ ਰੋਜ਼ ਲਾਉਂਦੇ ਆਈਲਾਈਨਰ ਅਤੇ ਕਾਜਲ, ਹੋ ਸਕਦਾ ਵੱਡਾ ਨੁਕਸਾਨ
ਸਿਹਤ

ਗਲੇ 'ਚ ਹੁੰਦੀ ਖਰਾਸ਼ ਤਾਂ ਹੋ ਸਕਦਾ ਇਨ੍ਹਾਂ ਗੰਭੀਰ ਬਿਮਾਰੀਆਂ ਦਾ ਖਤਰਾ, ਤੁਰੰਤ ਕਰਾ ਲਓ ਜਾਂਚ
ਸਿਹਤ

ਪੇਸ਼ਾਬ ਕਰਦੇ ਸਮੇਂ ਹੋਣ ਵਾਲੀ ਜਲਣ ਗੰਭੀਰ ਬਿਮਾਰੀਆਂ ਦਾ ਸੰਕੇਤ ਹੋ ਸਕਦੀ; ਡਾਕਟਰ ਤੋਂ ਜਾਣੋ ਇਲਾਜ ਤੇ ਲੱਛਣ
ਸਿਹਤ

ਬਰਸਾਤ ਦੇ ਮੌਸਮ ‘ਚ ਦਿਮਾਗ ਡੈਮੇਜ ਕਰ ਦਿੰਦਾ ਆਹ ਕੀੜਾ, ਜਾਣੋ ਇਸ ਦੇ ਲੱਛਣ ਅਤੇ ਬਚਾਅ
ਸਿਹਤ

ਰੇਬੀਜ਼ ਨੂੰ ਲੈ ਕੇ WHO ਦੀ ਗਾਇਡਲਾਈਨ; ਕੁੱਤੇ ਦੇ ਕੱਟਣ ਤੋਂ ਬਾਅਦ ਤੁਰੰਤ ਕਰੋ ਇਹ ਕੰਮ, ਬਚੋਂਗੇ ਇਨਫੈਕਸ਼ਨ ਤੋਂ
ਸਿਹਤ

ਕੁੜੀਆਂ ਦੀ ਇਸ ਗਲਤੀ ਕਰਕੇ ਹੁੰਦੀ ਯੂਰਿਨ ਇਨਫੈਕਸ਼ਨ, ਨਹੀਂ ਪਤਾ ਹੋਵੇਗਾ ਤੁਹਾਨੂੰ
Photo Gallery
ਸ਼ਾਟ ਵੀਡੀਓ Infection
Advertisement
Advertisement
Advertisement
ਟ੍ਰੈਂਡਿੰਗ ਟੌਪਿਕ